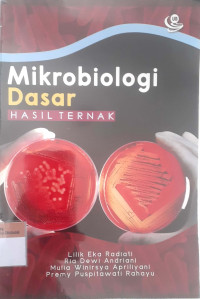
Mikrobiologi dasar hasil ternak

Buku Teks
Mikrobiologi dasar hasil ternak
Tidak Tersedia Deskripsi
Ketersediaan
| B04985 | 636 LIL M | Perpustakaan Universitas Pahlawan Tuanku Tambusai | Tersedia - Indonesia |
| B04984 | 636 LIL M | Perpustakaan Universitas Pahlawan Tuanku Tambusai | Tersedia - Indonesia |
Informasi Detail
- Judul Seri
-
-
- No. Panggil
-
636 LIL M
- Penerbit
- Malang : UB Press., 2019
- Deskripsi Fisik
-
xv, 142 hlm; 23 cm
- Bahasa
-
Indonesia
- ISBN/ISSN
-
978-602-432-922-8
- Klasifikasi
-
636 LIL M
- Tipe Isi
-
-
- Tipe Media
-
-
- Tipe Pembawa
-
-
- Edisi
-
Cet.1
- Subjek
-
-
- Info Detail Spesifik
-
-
- Pernyataan Tanggungjawab
-
-
Versi lain/terkait
Tidak tersedia versi lain
Lampiran Berkas
Komentar
Anda harus login sebelum memberikan komentar
 Karya Umum
Karya Umum  Filsafat
Filsafat  Agama
Agama  Ilmu-ilmu Sosial
Ilmu-ilmu Sosial  Bahasa
Bahasa  Ilmu-ilmu Murni
Ilmu-ilmu Murni  Ilmu-ilmu Terapan
Ilmu-ilmu Terapan  Kesenian, Hiburan, dan Olahraga
Kesenian, Hiburan, dan Olahraga  Kesusastraan
Kesusastraan  Geografi dan Sejarah
Geografi dan Sejarah